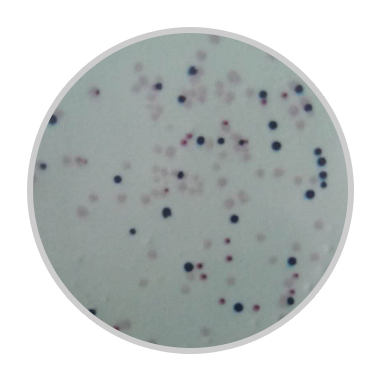

导航
导航
快速鉴定纸HiDtectTM是生物科学公司HiMedia 研发的专利产品,旨在快捷方便地对微生物进行各种鉴别鉴定。它已获得了欧盟的体外诊断注册证书,并经第三方实验室独立验证,能对病原菌进行快速可靠的检测。
HiDtectTM鉴定纸直径均为70mm,适用于90mm平皿。其操作过程较为简单,将鉴定纸覆盖在待鉴定菌落的普通培养基的表面,转印30秒至1分钟,再用镊子将鉴定纸转移到无菌平皿内,35-37℃孵育1-4小时,转印到鉴定纸上的菌落即可显色。不同菌属显现不同颜色,从而得以鉴别。
如下图为蔗糖发酵鉴定纸(示意图,黄色为阳性)

下图为肠道沙门菌鉴定纸(淡粉色为沙门氏菌,蓝色为大肠杆菌,无色为肺炎克雷伯菌)
快速鉴定纸HiDtectTM的原理仍为生化鉴定法,但它操作方便,菌落不用纯培养,且时间上显著缩短,从原先的24小时,缩短为1-4小时。且鉴定效率大大提高,可覆盖多个菌落,一次出结果,提前预知菌落属性,从而能够满足工业、临床等对快检的需求。
在制药工业,可用的HiDtectTM鉴定纸如下:
HiDtect七叶灵生化鉴定纸(DT014):用于鉴定肠球菌
HiDtect 总大肠菌群鉴定纸(DT012):可内部鉴别大肠菌群
HiDtect 芽孢杆菌鉴定纸(DT011):用于鉴定和内部鉴别芽孢杆菌
HiDtect鉴别鉴定纸(DT009):用于区分发酵乳糖的肠道菌和不发酵乳糖的肠道菌
HiDtect细菌限度纸(DT013):可检测药品中的大肠杆菌、金黄色葡萄球菌、铜绿假单胞菌和沙门氏菌。
具体检菌规定在《中国药典》上已有较为详细的规定,其中沉降菌检查用90mmTSA平板,有菌后可用DT012、 DT011和DT013进行鉴别。同样,在微生物计数方面,药典也指定的是90mmTSA平板(涂布法或倾注法)。计数后同样需要鉴别。如如药典规定,口服给药制剂允许有菌,但数量不能超标,且不得检出大肠埃希菌。含脏体提取物的制剂还不得检出沙门菌。又口腔粘膜给药制剂,要求控制菌不得检出大肠埃希菌,金黄色葡萄球菌、铜绿假单胞菌,因此可用DT013进行早期鉴别。
HiDtectTM鉴定纸并非对细菌的精准鉴定,但对常见菌具有较高的特异性,至少可作为初筛试验的一部分,为后面的鉴定条的选择或采用的其他精准鉴定方法提供参考。
同样,对于生产环境、制药用水、中药提取物和中药饮片的微生物检查,也可用HiDtect,只是注意生产环境的检查用的是55mm的平板,直径上并不合适(这时可采用HiMedia生产的HiTouch接触皿)。但其他检查用的是90mm的平板,则很方便。
对于药品控制菌所用的选择培养基,因其菌落可能带有颜色或特殊物质,直接采用HiDtect鉴定纸可能并不适合,但因该药同时要做微生物计数检查,因此用HiDtect直接鉴定无菌TSA上的菌落,会较为方便。
《中国药典》尤其提到,“建议对受控环境收集到的微生物进行适当水平的鉴定”,而HiDtectTM鉴定纸无疑是满足适当水平鉴定的一种理想选择。总之,HiDtectTM鉴定纸是可以被药厂广泛使用的。
扫二维码用手机看
亚洲精品无码成人A片色欲-性视频播放免费视频-这里是国产精品视频一区二区-久久精品人妻av-国产丰满老熟妇乱XXX
公司地址:河南省濮阳县铁丘路路南中稹绿探院内3号楼
联系电话:13137349799
E-mail:[email protected]
性视频播放免费视频
公司地址:河南省濮阳县铁丘路路南中稹绿探院内3号楼
联系电话:17310820029
E-mail:[email protected]
© 2021 亚洲精品无码成人A片色欲-性视频播放免费视频-这里是国产精品视频一区二区-久久精品人妻av-国产丰满老熟妇乱XXX ALL Rights Reserved 备案号:豫ICP备2023018085号 技术支持:新网